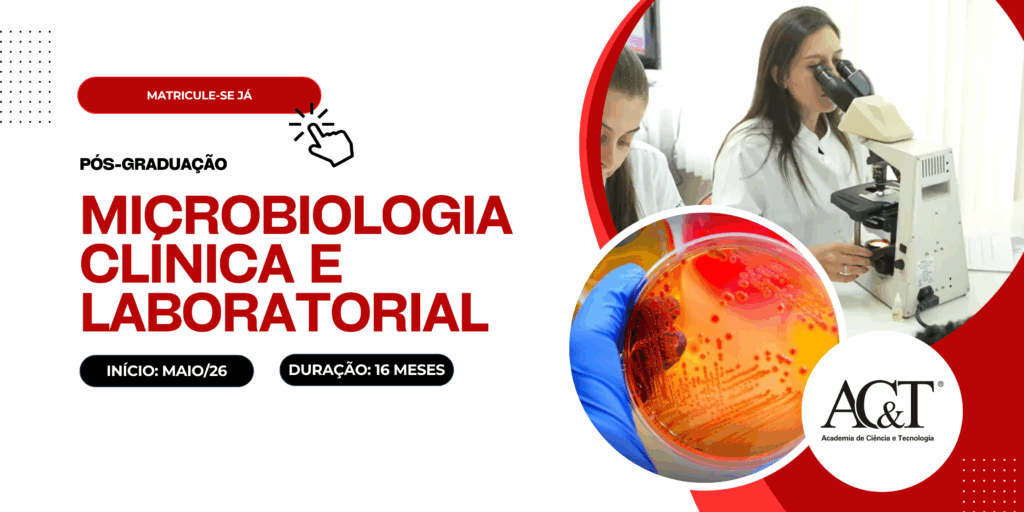

Duração e Estrutura
- Pós-graduação lato-sensu, em nível de Especialização
- Carga horária total: 16 meses. 360 horas.
- Módulos presenciais: 9 módulos com aulas práticas (na maioria deles), discussões de casos clínicos e aulas expositivas.
- Módulos a distância (EAD): 7 módulos on-line com dezenas de temas teóricos gravados, disponibilizados gradualmente conforme a programação.
Frequência mínima
- O curso conta com 9 módulos presenciais.
- O aluno deverá comprovar frequência mínima de 75% (participação em pelo menos 7 encontros presenciais).
Organização dos módulos presenciais
- Sábados: das 8h00 às 17h00 (com intervalos para coffee-break e almoço).
- Domingos: das 8h00 às 11h00.
Reconhecimento e Registro
O curso é registrado pelo MEC, em parceria com a Faculdade FACERES, e segue a orientação pedagógica para cursos de especialização contida na Resolução CSE/CES nº 01, de 06 de abril de 2018, bem como as diretrizes de consultoria pedagógica da instituição.
Diferenciais
- Acomodação gratuita nos Flats da AC&T, com duas pessoas em cada quarto. Há apartamentos para homens e mulheres, que são equipados com cozinha, banheiro, sala de TV e área de serviço.
- Transfer gratuito em Vans para os alunos (flats para AC&T e retorno)
- Café da manhã na AC&T e nos intervalos de aulas
- A Pós em Microbiologia da AC&T tem mais de 20 anos de existência
Investimento
16 parcelas mensais de R$ 690,00 (depósito mensal; transferência bancária ou PIX). Inclui (cortesia): acomodação em quartos para duas pessoas nos Flats da AC&T, transporte de van do Flat para a AC&T (ida e retorno), café da manhã e coffee-break. Pagamento à vista do valor total do curso tem 10% de desconto.
Garanta já a sua vaga – Taxa de Matrícula (R$150)
Corpo Docente

Coordenação Científica
Profa. Dra. Margarete Teresa Gottardo de Almeida. Bióloga. Mestre e Doutora pela Faculdade de Medicina de São José do Rio Preto (FAMERP). Responsável pelo laboratório de microbiologia da FAMERP. Professora adjunta da FAMERP. Orientadora dos programas de mestrado e doutorado de Pós-Graduação em microbiologia da UNESP. A Profa Margarete figura entre os cientistas mais influentes da América Latina segundo o ranking AD Scientific Index 2021.

Coordenação Geral
Prof. Dr. Flávio Augusto Naoum. Médico Hematologista. Mestre em Hematologia e Hemoterapia pela USP. Doutor em Medicina Interna pela FAMERP. Pós-doutorado em Hematologia pela Universidade de Middlesex (Inglaterra). Professor de Hematologia da Faculdade de Medicina FACERES de São José do Rio Preto, consultor em Hematologia do Laboratório Ultra-X, diretor do Instituto Naoum de Hematologia e diretor clínico da AC&T.
Cronograma das Aulas
30 e 31 de Maio de 2026 – PRESENCIAL
Introdução de Microbiologia no Laboratório de Análises Clínicas.
Biossegurança: Classificação dos Laboratórios (Níveis NB1,2 3 4).
Boas práticas no Laboratório Microbiológico.
Junho de 2026 – ONLINE*
Resposta imune – Revisão.
Imunodeficiências e infecções oportunistas.
*Interação online ao vivo sobre o tema com Prof. Dr. Flávio Naoum no dia 19/06 às 19h00.
25 e 26 de Julho de 2026 – PRESENCIAL
Fisiopatologia das infecções do trato respiratório.
Fisiopatologia das infecções do trato urinário.
Microrganismos prevalentes e emergentes
29 e 30 de Agosto de 2026 – PRESENCIAL COM PRÁTICA
Diagnóstico laboratorial das Infecções do Trato Respiratório e do Trato urinário considerando coleta, análises laboratoriais, pré e pós-analítica.
Apresentação e discussão de casos clínicos específicos.
Setembro de 2026 – ONLINE
Fisiopatologia das infecções do trato genital.
Fisiopatologia das infecções do trato gastrointestinal.
Microrganismos prevalentes e emergentes.
17 e 18 de Outubro de 2026 – PRESENCIAL COM PRÁTICA
Diagnóstico laboratorial das Infecções do Trato Genital e do Trato gastrointestinal considerando coleta, análises laboratoriais pré e pós-analítica.
Apresentação e discussão de casos clínicos específicos.
Novembro de 2026 – ONLINE
Fisiopatologia das infecções sistêmicas (sepse).
Fisiopatologia das infecções do Sistema Nervoso.
Microrganismos prevalentes e emergentes.
Mecanismo de ação e resistência aos antimicrobianos
12 e 13 de Dezembro de 2026 – PRESENCIAL
Diagnóstico laboratorial das Infecções Sistêmicas e do Sistema Nervoso Central considerando coleta, análises laboratoriais, pré e pós-analítica.
Apresentação e discussão de casos clínicos específicos.
Janeiro 2027 – ONLINE
Aula Metodologia científica – TCC
13 e 14 de Fevereiro de 2027 – PRESENCIAL COM PRÁTICA
Introdução à Micologia Médica;
Fungos patogênicos e oportunistas em humanos;
Infecções fúngicas superficiais.
Coleta de material clínico para exame micológico (Direto e Cultura).
Diagnóstico laboratorial para fungo de micoses superficiais (Fungos dermatófitos, não dermatófitos e leveduras).
Março de 2027 – ONLINE
Micoses sub-cutâneas: Cromomicose, Esporotricose.
Fungos prevalentes e emergentes.
17 e 18 de Abril de 2027 – PRESENCIAL COM PRÁTICA
Micetoma, Hialohifomicose, Feohifomicose.
Coleta e métodos diagnósticos laboratoriais para fungos de micoses subcutâneas.
Discussão de casos clínicos específicos.
Maio de 2027 – ONLINE
Micoses profundas e oportunistas: Paracoccidiomicose, Histoplasmose Coccidiomicose, Blastomicose, Aspergilose, Criptococose, Candidíase.
Doenças fúngicas emergentes.
12 e 13 de Junho de 2027 – PRESENCIAL COM PRÁTICA
Coleta e métodos diagnósticos laboratoriais para fungos de micoses profundas e oportunistas.
Discussão de casos clínicos específicos.
Mecanismo ação e resistência aos antifúngicos.
Antifungigrama.
Julho de 2027 – ONLINE
O Laboratório Microbiológico e as doenças virais.
RNA-vírus Família: Picornaviridae Rhabdoviridae Paramyxoviridae Togaviridae Flaviviridae. Retroviridae Coronaviridae.
DNA-vírus Família: Herpesviridae; Adenoviridae Papovaviridae Poxviridae Parvoviridae.
14 de Agosto de 2027 – PRESENCIAL
Indicações Up-to-date em microbiologia clínica.
Certificação e jantar de confraternização oferecido pela AC&T.
Veja como é um dia na Pós de Microbiologia da AC&T
“A AC&T é um lugar incrível” (Gabrielle, aluna da 13ª turma de Microbiologia)
